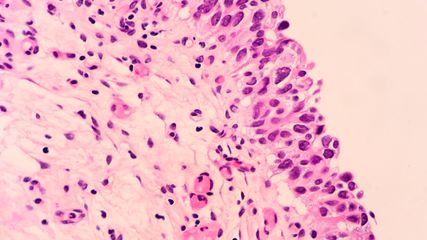

„Buried penis“: Herausforderungen in der rekonstruktiven Urologie
Autor:innen:
Prim. MUDr. Peter Weibl, PhD
Dr. Ghazal Ameli, FEBU
Ass. Dr. Anna Van Dellen
Abteilung für Urologie
Landesklinikum Korneuburg
E-Mail: anna.vandellen@hotmail.com
Sie sind bereits registriert?
Loggen Sie sich mit Ihrem Universimed-Benutzerkonto ein:
Sie sind noch nicht registriert?
Registrieren Sie sich jetzt kostenlos auf universimed.com und erhalten Sie Zugang zu allen Artikeln, bewerten Sie Inhalte und speichern Sie interessante Beiträge in Ihrem persönlichen Bereich
zum späteren Lesen. Ihre Registrierung ist für alle Unversimed-Portale gültig. (inkl. allgemeineplus.at & med-Diplom.at)
Die rekonstruktive Urologie erfordert zunehmend individualisierte operative Konzepte bei komplexen anatomischen und funktionellen Ausgangssituationen. Der „buried penis“ stellt dabei eine häufige klinische Entität dar und spiegelt exemplarisch die chirurgischen und strategischen Herausforderungen dieses Fachgebiets wider.
Keypoints
-
Die rekonstruktive Urologie umfasst ein breites Spektrum anspruchsvoller Eingriffe, deren Erfolg wesentlich von Erfahrung, anatomischem Verständnis und individueller Operationsplanung abhängt.
-
Der „buried penis“ ist ein funktionell relevantes Krankheitsbild mit steigender Prävalenz, für das bislang keine standardisierten Therapiealgorithmen existieren.
-
Eine strukturierte präoperative Evaluation einschließlich metabolischer Optimierung ist entscheidend für das funktionelle und ästhetische Ergebnis.
-
Aufgrund der Komplexität und der potenziellen Komplikationen sollten diese Eingriffe bevorzugt in spezialisierten Zentren durchgeführt werden.
Die rekonstruktive Urologie stellt ein breites Fachgebiet dar und umfasst alle chirurgischen Eingriffe zur Wiederherstellung des Urogenitaltrakts – von der Zirkumzision bis zur Neoblase reichend. Die häufigsten Verfahren sind rekonstruktive Eingriffe an der Harnröhre, etwa zur Behebung von Strikturen oder Fisteln sowie im Rahmen onkologischer Operationen. Darüber hinaus umfasst das Spektrum der rekonstruktiven Urologie jedoch eine Vielzahl weiterer komplexer Verfahren, darunter auch die penile und skrotale Rekonstruktion wie z.B. diverse Korrekturverfahren der „Induratio penis plastica“ (IPP), aber auch die Behandlung des „buried penis“ und plastische und rekonstruktive Einsätze bei Fournier-Gangrän.
Im Rahmen der Fortbildungstagung der ÖGU in Linz wurden die Herausforderungen der rekonstruktiven Urologie anhand von diversen Fallbeispielen vorgestellt. Diese basierten auf Erfahrungen aus dem klinischen Alltag des Landesklinikums Korneuburg, das viele dieser Eingriffe durchführt. Zu den wichtigsten Grundlagen in der operativen Versorgung zählen fundierte anatomische Kenntnisse, Erfahrungen in der Anwendung von Gewebesubstituten sowie umfassendes Wissen über Wundheilung und die entsprechenden Verbandstechniken.
„Buried penis“ als rekonstruktive Herausforderung
Im vorliegenden Artikel sollen die Herausforderungen der rekonstruktiven Urologie exemplarisch am Beispiel des „buried penis“ skizziert werden.
Der „buried penis“ ist eine anatomische Anomalie mit zunehmender klinischer Relevanz insbesondere im Bereich der rekonstruktiven Urologie. Der Penis ist dabei trotz normaler anatomischer Entwicklung teilweise oder vollständig unter die umgebende Haut von Abdomen, Skrotum oder Perineum verlagert. Während diese Entität im Kindesalter selten auftritt und ihr überwiegend kongenitale Ursachen zugrunde liegen, tritt die erworbene Form beim Erwachsenen zunehmend häufiger im Zusammenhang mit Adipositas, chronischen Entzündungen oder postoperativen Veränderungen auf. Dies kann mit erheblichen funktionellen Einschränkungen wie Miktionsstörungen, rezidivierenden Infektionen und sexueller Dysfunktion einhergehen, was häufig eine deutliche Beeinträchtigung der Lebensqualität zur Folge hat.
Die chirurgische Rekonstruktion des „buried penis“ ist herausfordernd und erfordert ein individualisiertes Vorgehen unter Berücksichtigung der zugrunde liegenden Ätiologie, des Ausmaßes der Gewebe- und Weichteilveränderungen, aber vor allem auch der funktionellen Zielsetzung. Aufgrund der geringen Datenlage gibt es zum aktuellen Zeitpunkt keinen standardisierten Therapiealgorithmus.
Präoperatives Assessment
Wie bei den meisten rekonstruktiven Eingriffen spielt das genaue präoperative Assessment der anatomischen Gegebenheiten sowie auch des umliegenden Weichteilgewebes daher eine maßgebliche Rolle. Dazu zählen neben der Diagnostik etwaiger Harnröhrenstrikturen und Miktionsstörungen auch die Evaluierung einer erektilen Dysfunktion. Essenziell in Bezug auf die postoperative Zufriedenheit sind auch die ausführliche Aufklärung hinsichtlich des zu erwartenden funktionellen sowie kosmetischen Resultats und die sorgfältige Dokumentation.
Da der „buried penis“ häufig als Folge von Adipositas auftritt und Adipöse daher einen Großteil des Patientenkollektivs ausmachen, sind auch die metabolische Abklärung sowie die Optimierung der damit einhergehenden Komorbiditäten wie Gewichtsverlust oder Blutzuckereinstellung von maßgeblicher Relevanz.
Chirurgische Therapieansätze & Operationsstrategien
Die operative Therapie des „buried penis“ beinhaltet zunächst die Freilegung des Penisschaftes („penis degloving“) sowie im Anschluss die Wiederherstellung einer funktionell und ästhetisch adäquaten penilen Hautdeckung (Abb.1). Zentrale operative Schritte umfassen die Lösung des Penis aus umgebenden Weichteilstrukturen, die Resektion von überschüssigem suprapubischem Fett- und Hautgewebe (Escutcheonektomie) sowie gegebenenfalls eine abdominelle Pannikulektomie (oder a.g. die Entfernung einer stark überhängenden Fettschürze am Bauch).
Abb. 1: Operative Schritte – Bild A + B: Freilegung des Penisschaftes („degloving“) aus dem umgebenden Weichteilgewebe; Bild C: Fixation des Penisschaftes; Bild D: Entnahme eines Spalthauttransplantats; Bild E: Mesh-Spalthauttransplantat zur Deckung des penilen Hautdefekts
Abhängig vom Zustand der penilen Haut kommen lokale Hautlappen oder Hauttransplantate zum Einsatz. Aufgrund von vorgeschädigter peniler Haut als Folge von chronischen Entzündungen, Lichen sclerosus oder Verwachsungen kommt die penile Haut häufig nicht für ein lokales Hauttransplantat infrage. Sollten Teile der penilen Haut dennoch erhaltungsfähig sein, können skrotale Hautlappen zur Rekonstruktion eingesetzt werden.
Dabei wird zunächst ein ventraler Längsschnitt zur Freilegung der Glans durchgeführt. Anschließend wird eine Inzision entlang der medianen Skrotalraphe vom mittleren Penisschaft bis in das mittlere Skrotum fortgeführt. Von dort aus erfolgt ein horizontaler Schnitt auf Höhe des mittleren Skrotums zur Anlage eines Rotationslappens, sodass der ventrale penile Hautdefekt gedeckt werden kann. Dadurch kann die dorsale penile Haut erhalten werden. Gelegentlich kann auch eine Fixation der penilen Haut an der Buckfaszie erforderlich sein, um ein Rezidiv zu verhindern. Bei Betroffenen nach Penisteilresektion kann auch die Durchtrennung von Ligamenten zur optischen Verlängerung des Penis durchgeführt werden.
Sollte ein Erhalt der penilen Haut nicht möglich sein, können sowohl Spalthaut- als auch Vollhauttransplantate eingesetzt werden. Die gängigste Methode beinhaltet die Entnahme eines Spalthauttransplantats vom anterioren Oberschenkel mit anschließendem Einsatz am Penisschaft. Als alternative Methode besteht im Falle einer Pannikulo- bzw. Escutcheonektomie auch die Möglichkeit, ein Transplantat vom resezierten Panniculus zu entnehmen und als „mesh-graft“ einzusetzen. Neben Spalthauttransplantaten kommen auch immer häufiger Vollhauttransplantate zum Einsatz. Die Vorteile von Spalthauttransplantaten sind die schnellere Wundheilung im Bereich der Entnahmestelle sowie eine raschere Einheilung im Vergleich zum Vollhauttransplantat. Es kommt jedoch häufiger zu Retraktionen, was insbesondere bei jungen Betroffenen mit guter Potenz zu funktionellen Problemen bei der Erektion führen kann. Es gibt daher vor allem bei diesem Patientenkollektiv in den letzten Jahren die Tendenz, eher Vollhauttransplantate zur Deckung des Hautdefekts einzusetzen.
Nach der operativen Versorgung ist eine adäquate Wundbehandlung entscheidend für ein zufriedenstellendes postoperatives Ergebnis. Der VAC-Verband spielt hierbei eine wichtige Rolle, da er sowohl als sog. „Tie-over“-Verband am penilen Rekonstruktionsareal als auch an der Hautentnahmestelle die Wundheilung unterstützt, indem er die Granulationsgewebsbildung fördert und ein optimales Wundmilieu schafft (Abb.2).
Abb. 2: Wundversorgung – Bild F: „Tie-over“-VAC-Verband, Bild G + H: VAC-Versorgung der Entnahmestelle
Zur Übersicht haben Pariser et al. 2018 ein vereinfachtes Klassifikationssystem für den komplexen Eingriff mit folgenden Stufen veröffentlicht:
-
Penisfreilegung mittels lokalen Hautlappens
-
Verwendung von Hauttransplantaten
-
skrotale Rekonstruktion
-
Escutcheonektomie
-
abdominelle Pannikulektomie
Datenanalysen deuten darauf hin, dass mit zunehmender Klassifikationsstufe die Komplikationsrate ansteigt. Hierzu zählen Wundheilungsstörungen, Serom- oder Hämatombildungen, partielle Hautnekrosen bzw. Transplantatverlust sowie funktionelle Einschränkungen wie persistierende Miktionsstörungen, Meatusstenosen oder Rezidive. Selten treten auch Sensibilitätsstörungen der Glans und eine erektile Dysfunktion auf.
Zusammenfassung & Ausblick
Der „buried penis“ stellt eine anspruchsvolle klinische Entität innerhalb der rekonstruktiven Urologie dar, die eine sorgfältige präoperative Evaluation und ein individuell angepasstes chirurgisches Vorgehen erfordert. Trotz zunehmender klinischer Relevanz fehlen bislang standardisierte Therapiealgorithmen, sodass die operative Strategie maßgeblich vom individuellen Therapieentscheid, aber auch von der Expertise des Operateurs/der Operateurin abhängen. Da diese Eingriffe Erfahrung benötigen, sollten sie bevorzugt in spezialisierten Zentren bzw. von in diesem Gebiet spezialisierten Chirurg:innen durchgeführt werden. Zukünftige Studien mit größeren Fallzahlen sind notwendig, um evidenzbasierte Behandlungskonzepte zu etablieren und funktionelle wie auch ästhetische Langzeitergebnisse weiter zu optimieren.
Literatur:
● Fuller TW et al.: Surgical management of adult acquired buried penis: escutcheonectomy, scrotectomy, and penile split-thickness skin graft. Urology 2017; 108: 237-8 ● Ho TS, Gelman J: Evaluation and management of adult acquired buried penis. Transl Androl Urol 2018; 7(4): 618-27 ● Kumar T et al.: Use of suprapubic panniculus for split-thickness skin graft in buried penis repair. Eplasty 2024; 24: e6. PMID: 38476520 ● Pariser JJ et al.: A simplified adult acquired buried penis repair classification system with an analysis of perioperative complications and urethral stricture disease. Urology 2018; 120: 248-52 ● Stephen JR, Burks FN: Buried penis repair: tips and tricks. Int Braz J Urol 2020; 46(4): 519-22
Das könnte Sie auch interessieren:
Vom Siegeszug der ADC und von neuen Active-Surveillance-Therapieansätzen
Auf dem 11. Michael J. Marberger Meeting der Universitätsklinik für Urologie, Medizinische Universität Wien, wurden aktuelle Daten zu Antikörper-Wirkstoff-Konjugaten, neue Ansätze zum ...
Heutiger Stellenwert der ESWL: Renaissance in Sicht?
Die ESWL (extrakorporale Stoßwellenlithotrypsie) ist eine Technik zur urologischen Steintherapie, die in den 80er-Jahren des vorigen Jahrhunderts in den klinischen Alltag Einzug gehalten ...
PCNL-Indikationen in Zeiten von flexibler Ureterorenoskopie mit Absaugung?
In der Behandlung von Nierensteinen, die größer als 2cm sind, spielt die perkutane Nephrolithotomie (PCNL) weiterhin eine wichtige Rolle. Die flexible Ureterorenoskopie (URS) mit ...